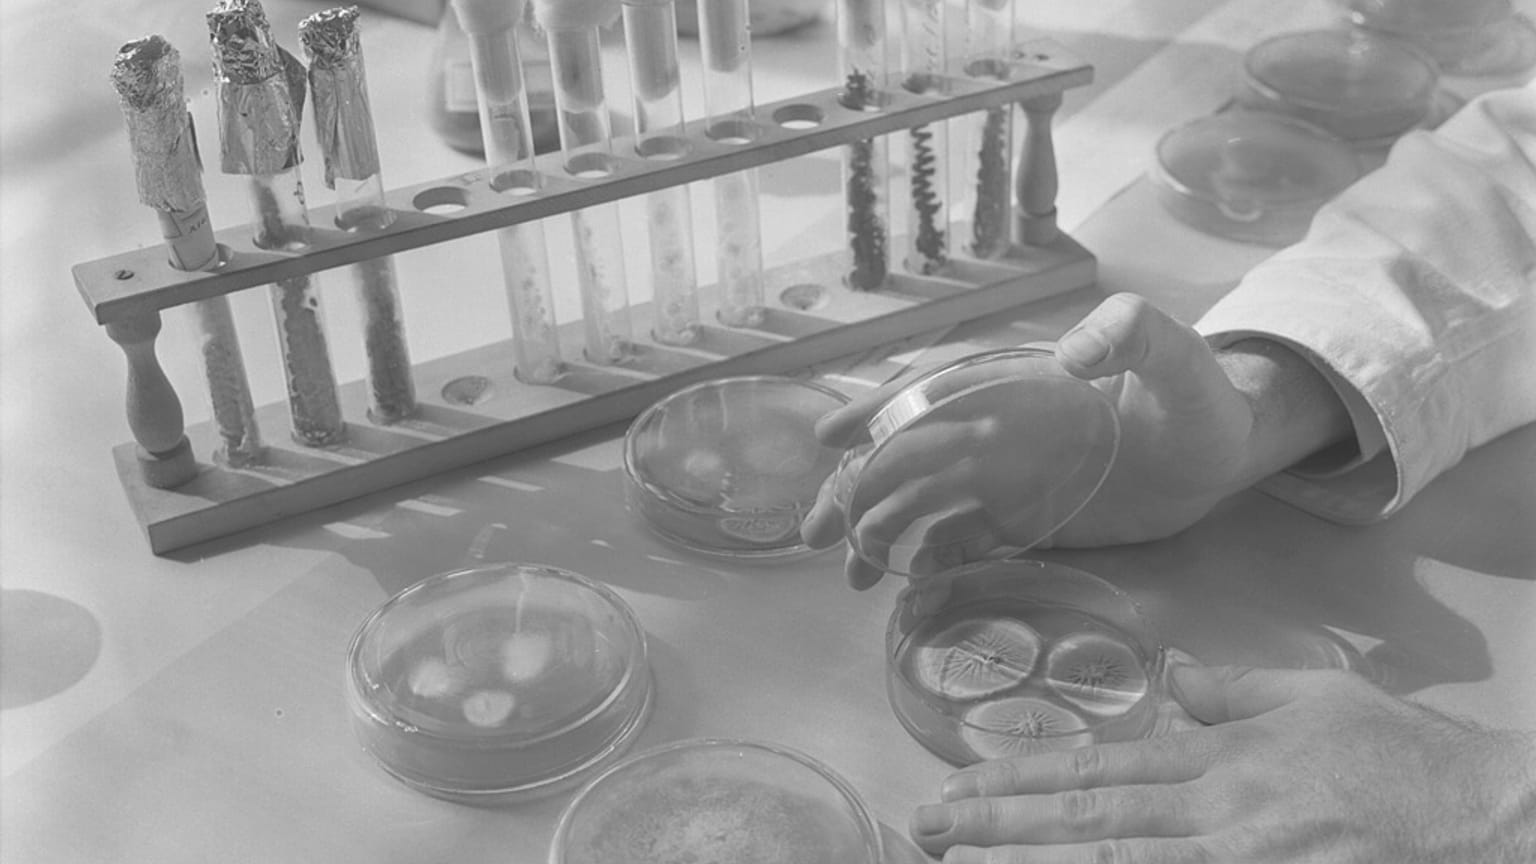
مخبر طبي

تُعد البلاعم من أبرز الخلايا المناعية التي تراقب المواقع الحاجزية كالرئة والأمعاء أثناء العدوى
كشفت دراسة حديثة أجراها باحثون في جامعة لانكستر أنّ فئة من المضادات الحيوية المعروفة باسم الفلوروكينولونات" قادرة على تعديل قدرة خلية مناعية رئيسية ــ تسمى البلاعم (نوع من خلايا الدم البيضاء) ــ على التخلص من البكتيريا، ليس عبر قتلها مباشرة، بل بإعادة تشكيل وظيفتها الخلوية.
 اعلان
اعلان
 اعلان
اعلان
ويكتسب هذا الاكتشاف أهميته الخاصة في سياق الرئة، العضو الذي يوازن باستمرار بين امتصاص الأكسجين وإطلاق ثاني أكسيد الكربون، في ظل تعرّضه المستمر لمسببات الأمراض الجوّية. ولذلك، تستضيف أنسجته تشكيلة واسعة من الخلايا المناعية المصممة للتصدي لهذه التهديدات، لكن هذه الآليات الدفاعية قد تفشل أحيانًا، ما يؤدي إلى عدوى تنفسية خطيرة.
وتُعد البلاعم من أبرز الخلايا المناعية التي تراقب المواقع الحاجزية كالرئة والأمعاء أثناء العدوى. وتتميّز بقدرتها على إنتاج جزيئات سامة تقتل البكتيريا، بالإضافة إلى "التهام" الجراثيم المحيطة بها، وهي عملية تُعرف باسم "البلعمة".
مثل جميع الخلايا البشرية، تحتوي البلاعم على ميتوكندريا مسؤولة عن توليد الطاقة. وقد سبق أن بيّنت أبحاث أن هذه العضيات تطوّرت من أسلاف بكتيرية، ولا تزال تحتفظ بمسارات جزيئية يمكن أن تستهدفها بعض المضادات الحيوية.
تأثير مباشر على الأيض الخلوي
أظهرت نتائج الدراسة، المنشورة في مجلة Discovery Immunology، أن الفلوروكينولونات لا تقتل ميتوكندريا البلاعم، بل تُجهدها بشكل مباشر، فتغيّر أيضها إلى حالة تُحسّن قدرتها على التخلص من البكتيريا.
وقال الباحث الرئيسي الدكتور جون وورثينغتون من قسم العلوم الطبية الحيوية والحياة في جامعة لانكستر: "ركّزت ملاحظات سابقة كثيرة على استخدام المضادات الحيوية أثناء العدوى البكتيرية، حيث يصعب تمييز تأثيراتها المباشرة على الجهاز المناعي.
وأضاف، "حين فحصنا أنواعاً متعددة من خلايا الرئة المناعية خلال علاج بالمضادات الحيوية في غياب العدوى، لاحظنا ارتفاعاً في مستويات إنزيم يُدعى 'أكسيد النيتريك inducible' (iNOS)، وهو المسؤول عن إنتاج جزيء أكسيد النيتريك القاتل للبكتيريا".
وقال: "من المثير أن هذا التأثير حدث فقط في أنواع معيّنة من الخلايا المناعية. ففي كلٍّ من الأمعاء والرئة، كانت الفئات الفرعية الأصغر سناً من البلاعم هي الوحيدة المتأثرة، وليس السكان البلازميين طويلي العمر."
تأكيد مخبري على التأثير المباشر
وأضاف الدكتور أليكس هاردغريف، أحد المؤلفين الأولين: "نظراً لتعدد العوامل التي قد تفسّر ملاحظاتنا الأولية في الرئة والأمعاء، قمنا بتنمية البلاعم في المختبر، فلاحظنا مجدداً ارتفاع تعبير iNOS، وتحسّن قدرة البلاعم على البلعمة أو 'ابتلاع' البكتيريا، ما يثبت وجود تأثير مباشر للمضاد الحيوي على البلاعم."
وتُعد المضادات الحيوية العلاج الأساسي للحد من المضاعفات الخطيرة في العديد من عدوى الرئة البكتيرية، إذ تعمل على تثبيط نمو البكتيريا أو قتلها. لكن استخدامها قد يترافق مع آثار جانبية سلبية، منها استهداف البكتيريا المفيدة في أجسامنا.
وصرّحت الدكتورة ميغان دولي، المشاركة في التأليف الأول: "سبق أن أظهرت الآثار الجانبية لاستخدام الفلوروكينولونات انخفاضاً في ميكروبيوم الجسم الأساسي، وفقدان الوزن، وتلف الأوتار خلال الاستخدام الطويل، وربما يعود ذلك إلى تلف الميتوكندريا. ومع ذلك، تضيف هذه الدراسة إلى الأدلة القائلة بأن للمضادات الحيوية خصائص منظِّمة للمناعة قد تنطوي على فوائد وأضرار لا يدركها معظم الناس."
وأردف الدكتور وورثينغتون محذراً: "قد يبدو الجمع بين وظيفتين ــ قتل البكتيريا مباشرةً ودعم وظيفة البلاعم لاستهدافهاــ مزيجاً مثالياً. لكن الالتهاب غير المنضبط قد يلحق ضرراً بأنسجتنا الخاصة، فيكون الضرر أكثر من النفع. ومع ذلك، فإن إدخال هذه المعرفة ضمن خياراتنا العلاجية عند اختيار فئة المضاد الحيوي الأنسب قد يمكّننا من تحديد العلاج الأكثر فائدة لاحتياجات كل مريض على حدة".